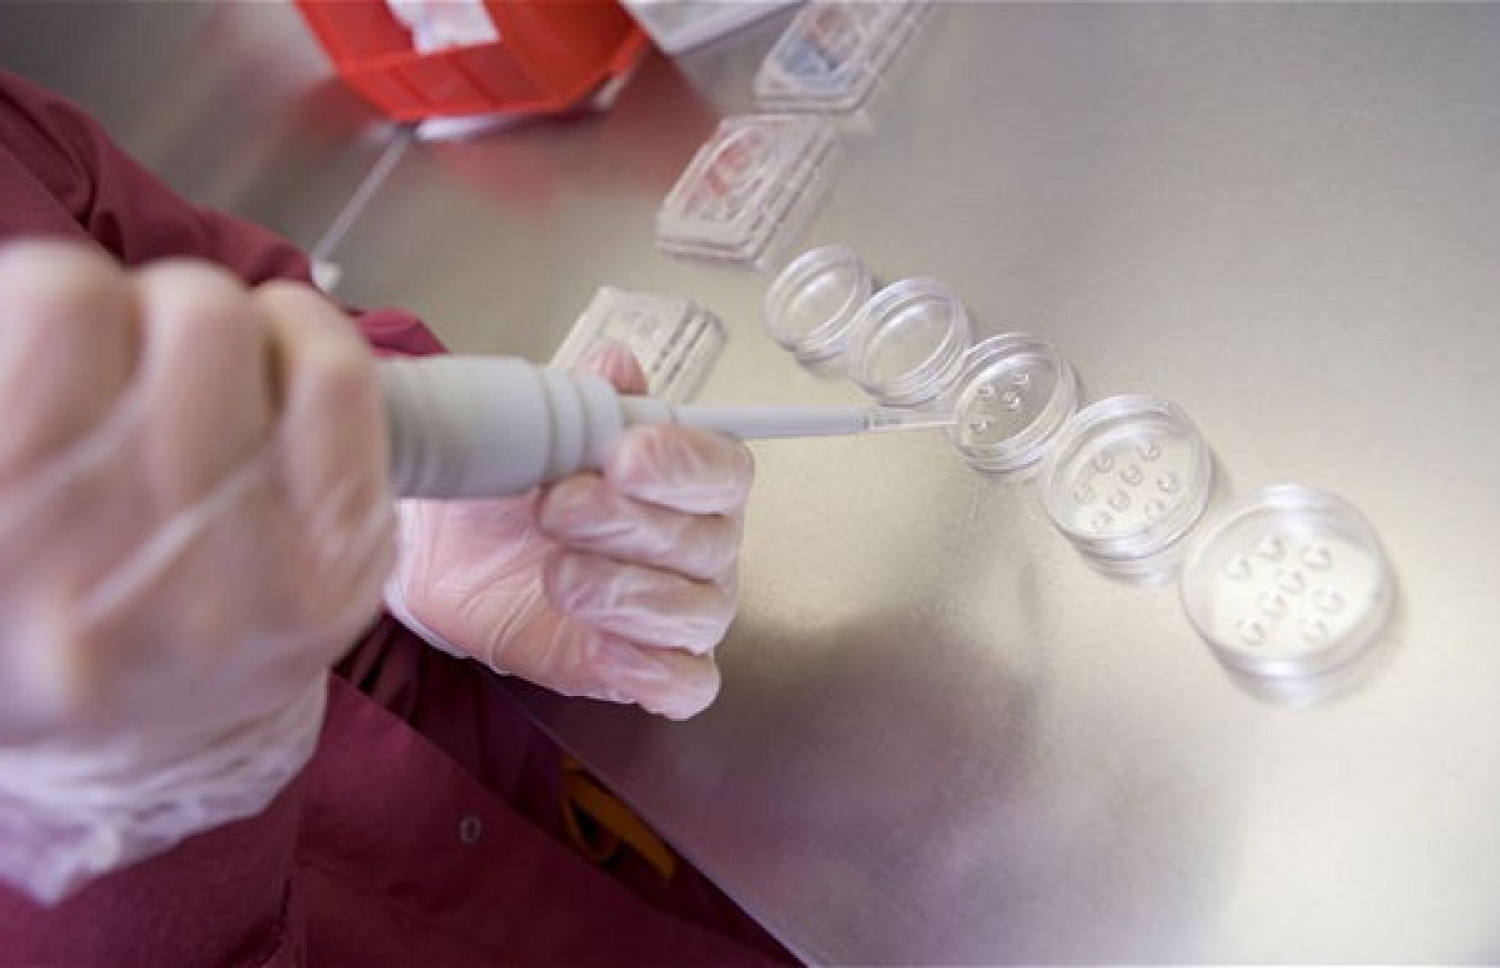

ދަރިން ނުލިބޭ މީހުން ހޯދާ ފަރުވާތަކުގެ ތެރެއިން އެއް ފަރުވާ އަކީ އިން ވިޓްރޮ ފާޓިލައިޒޭޗަން (އައިވީއެފް) އެވެ. އެކަމަކު މި ފަރުވާ ހޯދާ އެންމެންނަކީ ހަމަ ކޮންމެހެން ވެސް މި ފަރުވާ ހޯދަން ޖެހޭ މީހުންތޯ ތަޖުރިބާކާރުން މިހާރު ސުވާލު އުފައްދަ އެވެ.
އިނގިރޭސި ވިލާތުގެ އިންފާޓިލިޓީ އެކްސްޕާޓުން ދެކޭ ގޮތުގައި އިނގިރޭސި ވިލާތުގައި އެކަނިވެސް އައިވީއެފްގެ ފަރުވާ ހޯދާ އެތައް ހާސް އަންހެނުންނަކީ ހަގީގަތުގައި އެ ފަރުވާ ކޮންމެހެން ހޯދަން ޖެހޭ މީހުންނެއް ނޫނެވެ. އޭގެތެރެއިން ގިނަ މީހުންނަކީ ގުދުރަތީ ގޮތުން ވެސް ދަރިން ހޯދިދާނެ މީހުންނެވެ.
ދިރާސާތަކުން ދައްކާ ގޮތުގައި ދަރިން ބޭނުންވެގެން އުޅޭ ދެމަފިރިންނަށް އެއް އަހަރު މަސައްކަތްކުރުމުން ދަރިން ލިބުމުގައި ކާމިޔާބު ނުވިޔަސް އެއީ ދަރިން ނުލިބެނީ ކަމަށް ބަލައިގެން ނުވާނެ އެވެ. ދެ އަހަރު ވަންދެން ހުއްޓުމެއް ނެތި މިފަދަ ދެމަފިރިން މަސައްކަތް ކޮށްފި ނަމަ ދަރިއަކު ލިބުމުގެ ފުރުސަތު އިތުރުވެގެންދެ އެވެ.
ބްރިޓިޝް ފާޓިލިޓީ ސޮސައިޓީ ކޮންފަރެންސްގައި ވާހަކަ ދެއްކި ބޭފުޅުން ވިދާޅުވީ ދަރިއަކު ހޯދަން މަސައްކަތްކުރާތާ އަހަރެއްހާ ދުވަސް ތެރޭ ބަލިވެ ނީނދެއްޖެ ނަމަ ގިނަ މީހުން ވަރަށް ހާސްވާ ކަމަށެވެ. އަދި އަވަހަށް އައިވީއެފް ހަދަން އެތައް ހާސް ޑޮލަރެއް ޚަރަދު ކުރެ އެވެ. ސިއްހީ މައްސަލައެއް ހުރި ކަމަށް ގަބޫލުކުރެވެނީ އެވެ.
ޔުނިވަސިޓީ އޮފް އެބަޑީންގެ ޕްރޮފެސާ ސިލަދިތުޔާ ބަޓަޗާރިޔާ ވިދާޅުވީ މިގޮތަށް ވިސްނެނީ ދަރިއަކުން ހޯދަން ވަރަށް ބޮޑަށް ބޭނުންވެގެން ދަރިން ހޯދަން މަސައްކަތް ފަށާތީ ކަމަށެވެ.
ގުދުރަތީ ގޮތުން ބަލިވެ އިނުމަށް ނުކުޅެދިފައިވާ ބައެއް މީހުންނަށާއި އުމުރުން 40 އަހަރު ވުމުން ދަރިން ހޯދަން ބޭނުންވާ ބައެއް މީހުންނަށް އައިވީއެފްގެ އެހީތެރިކަން ލިބުނަސް ބައެއް މީހުން ބޭނުމެއް ނެތް ބޮޑެތި ޚަރަދުތަކަކާއި ވަގުތުތަކެއް ހޭދަކޮށް އޯވަރީޒްތައް ސްޓިމިއުލޭޓްކުރަން އެތައް ބައިވަރު ބޭސްތަކެއް ބޭނުންކޮށް، އައިވީއެފްގެ ފަރުވާ ހޯދަނީ ހަގީގަތުގައި ޑޮކްޓަރެއް ކައިރިއަށް ދުވަހަކު ނުގޮސް ވެސް އެމީހުން ބަލިވެ އިނުމުގެ ފުރުސަތު އޮއްވަ އެވެ.
އެޑިންބާގްގައި މި ހަފުތާގައި އޮތް ކޮންފަރެންސްގައި ވާހަކަ ދައްކަވަމުން ޑރ. ބަޓަޗާރިޔާ ވިދާޅުވީ އައިވީއެފުން ކުރާ ފައިދާ އަށް ތާއީދުކުރާ ހެކިތަކަށް ބަލާއިރު އެ ފަރުވާއާ ނުލައި ގުދުރަތީ ގޮތުން ބަލިވެ އިނުމުން މާ ރަނގަޅުކަމަށް ބެލެވޭ ކަމަށެވެ. އަދި އައިވީއެފް އަށް ކުރާ ބޮޑު ހޭދަ އާއި ވަގުތާ މެދު އެއްޗެއްކަން ބުނަން ފަސްޖެހޭ ކަމަށެވެ.
ފުރަތަމަ ޓެސްޓް ޓިއުބު ބޭބީ ލުއިސް ބްރައުން އުފަންވިތާ މިހާރު 40 އަހަރު ވެފައި ވިޔަސް އައިވީއެފް މަސައްކަތްކުރާލެއް ރަނގަޅު ކަމުގެ ހެކިތައް ލިބިފައިވަނީ ވަރަށް ވަރަށް މަދުންނެވެ.
ޖާނަލް އޮފް ހިއުމަން ރިޕްރޮޑަކްޝަންގައި 2010 ގައި ޝާއިއުކޮށްފައިވާ ދިރާސާއެއްގައިވާ ގޮތުން ދަރިން ނުލިބިގެން އައިވީއެފް ހަދާ ދެމަފިރިންގެ ތެރެއިން ކަނޑައެޅިގެން އައިވީއެފް ހަދައިގެން ކަން ސާބިތުވާ ފަދަ ގޮތަކަށް ދަރިން ލިބިފައިވަނީ އެންމެ 13 ޕަސެންޓް މީހުންނަށެވެ. ދެން ތިބި މީހުންގެ ތެރެއިން ގިނަ މީހުން ބަލިވެ އިނދެފައިވަނީ ގުދުރަތީ ގޮތުންނެވެ. އަނެއް ބަޔަކު އެހެން ފަރުވާ އަކުންނެވެ.
އަދި ޑެންމާކްގައި ހަދާފައިވާ އެހެން ދިރާސާއަކުން ދެއްކި ގޮތުގައި އައިވީއެފް ހަދާ މީހުންގެ ތެރެއިން ތިންބައިކުޅަ އެއްބައި މީހުންނަކީ ހަގީގަތުގައި އެ ފަރުވާ ބޭނުންވެގެން އެކަންކުރާ ބައެއް ނޫނެވެ. އެފަދަ މީހުންނަށް އެއްވެސް ކަމެއް ނުކުރިޔަސް ދަރިން ލިބުމުގެ ފުރުސަތު ވަރަށް ބޮޑަށް އޮވެމެ އެމީހުން ބޭކާރު އެތައް ބައިވަރު ފަރުވާތަކެއް ހޯދަނީ ބޭނުމެއް ނެތި އެވެ.
މި ކޮންފަރެންސްގައި ޕްރޮފެސާ ބަޓަޗާރިޔާ ވިދާޅުވީ ދަރިމައިވުމުގެ ނިޒާމަކީ ވެސް "ސްވިޗެއް" އިންނަ އެއްޗެއްގެ ގޮތުގައި ގިނަ ބަޔަކަށް ހީވާ ކަމަށެވެ. ދަރިން ހޯދަން ބޭނުން ނުވާ މީހުން ދޭތެރެ ދުރުކުރާ ވަސީލަތްތަކުގެ ބޭނުންކޮށްގެން އެ ސްވިޗް އޯފް ކޮށްލާ ގޮތަށް ދަރިން ބޭނުންވާ ވަގުތު އެ ސްވިޗް އޮން ވާންޖެހޭނެ ކަމަށް އެފަދަ މީހުންނަށް ގަބޫލު ކުރެވޭ ކަމަށް އޭނާ ވިދާޅުވި އެވެ.
"ބަލިވެ އިނުން ދުރުކުރަނީ ވެސް ޑިމާންޑާ އެއްގޮތަށް ކަމުން ހަމަ އެ ޑިމާންޑާ އެއްގޮތަށް ބަލިވެ އިންނަން ޖެހޭނެކަމަށް ގަބޫލު ކުރެވިފައި އޮންނަނީ،" އޭނާ ވިދާޅުވި އެވެ.
އޭނާ ވިދާޅުވީ މިޒަމާނުގައި މީހުން ދަރިން ވެސް ބޭނުންވަނީ އެބަޔަކު އެ ބޭނުންވާ ވަގުތަކު އެވެ. މިހާރު ހުރިހާ ކަމެއް ވެސް ވަގުތުން ވަގުތަށް ކުރެވެން އޮންނަ ޒަމާނަކަށް ވާތީ ހިތަށް އެރި އިރަކުން ބަލިވެ އިންނަން ޖެހޭނެކަމަށް މީހުންނަށް ގަބޫލު ކުރެވިފައި ވަނީ އެވެ.

ދަރިން ނުލިބިގެން ފަރުވާ ހޯދަން މަސައްކަތްކުރަންޖެހޭ ގޮތުގެ ގައިޑްލައިން ބުނާ ގޮތުން ދަރިން ނުލިބޭތީ ފަރުވާއެއް ހޯދަން ޚިޔާލުކުރަން ޖެހޭނީ މަދުވެގެން ދެ އަހަރު ދުވަހު މަސައްކަތް ކޮށްގެން ދަރިއަކު ނުލިބިއްޖެނަމަ އެވެ.
ދި އެބަޑީން ފާޓިލިޓީ އެކްސްޕާޓު ވިދާޅުވަނީ ބަލިވެއްޖެ ނަމަ ފަރުވާ ހޯދުމަކީ އޮންނަ ގޮތް ކަމަށް ވާއިރު ބަލިވެ ނީނދެގެން ދަރިން ހޯދުމަށް ފަރުވާ ހޯދާ މީހުންނަށް ވެސް ހިނގާނީ މި އުސޫލެވެ. ދަރިން ނުލިބޭތީ އެއްވެސް ކަމެއް ނުކޮށް ހުރުމަށްވުރެ އައިވީއެފްގެ ފަރުވާ ހޯދުން ރަނގަޅު ކަމަށްވާ ނަމަ އެކަމުގެ އިތުރު ހެކިތައް ހޯދުމަށް ޕްރޮފެސަރު ގޮވާލެއްވި އެވެ.